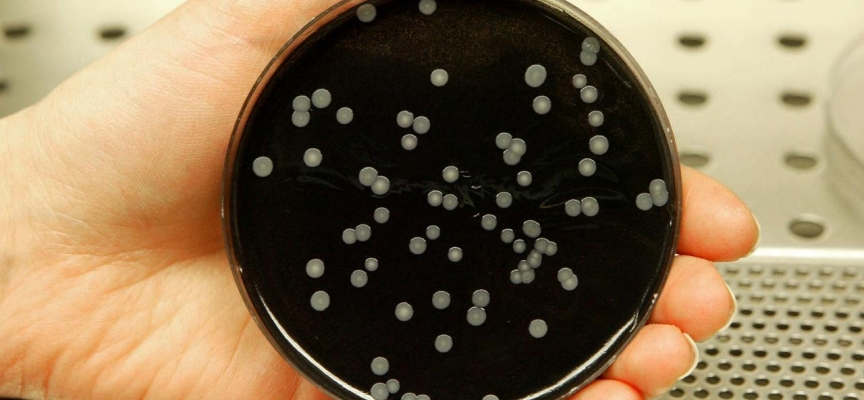

Tucuman Eyaleti Sağlık Bakanlığı, legionella virüsünün sebep olduğu zatürreden 6 kişinin öldüğünü, toplam 13 kişinin de hastalığa yakalandığını açıkladı.
Tucuman Eyaleti Sağlık Bakanı Luis Medina Ruiz, gazetecilere yaptığı açıklamada, "En az 8 yeni hasta daha tespit ettik. Bunlardan biri (klinikteki) hastalardandı, 2'si sağlık çalışanı ve 5'i de hasta bakıcı" dedi.
Hayatını kaybeden son iki hastanın 64 ve 81 yaşlarında olduğunu, bu kişilerin farklı sağlık sorunlarının bulunduğunu aktaran Ruiz, hastalığa yakalananlardan ikisinin durumunun ağır ve solunum cihazına bağlandığını belirtti.
Klinik dışında kimsede görülmedi
Luz Medice isimli klinikte ortaya çıkan hastalık için Ruiz, tüm hastaların klinikle bağlantılı olduğunu, klinik dışında bir hastanın görülmediğini söyledi.
Bakterinin sebep olduğu hastalık geçen hafta ortaya çıkmış, bir doktor ve hemşirenin ölümüne neden olmuştu. Hastalığın ilk başlarda ne olduğu belirlenemediği için endişeye yol açmıştı.
Arjantin Sağlık Bakanlığı, akciğer hastalığına legionella bakterisinin neden olduğunu açıklamıştı. Bakanlık, hangi tür olduğu üzerine çalışmaların devam ettiğini ancak legionella pneumophila enfeksiyonuna (lejyoner hastalığı) sebep olan legionella bakterisinden şüphelenildiğini kaydetmişti.
Bakanlık, bakterinin su veya merkezi havalandırma sistemleri vasıtasıyla solunum yoluyla bulaştığını, hastalığın insandan insana bulaşmadığını duyurmuştu.
TRT

Türkçe karakter kullanılmayan ve büyük harflerle yazılmış yorumlar onaylanmamaktadır.